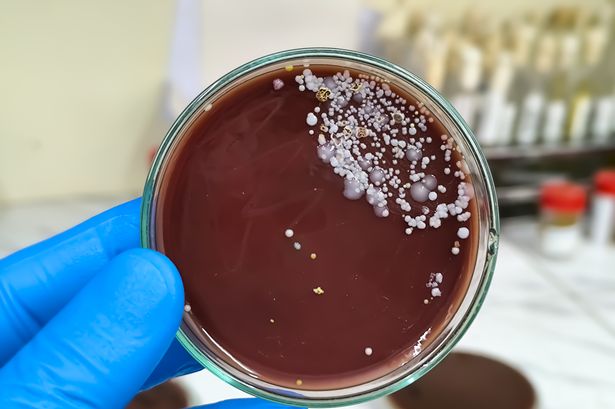

Scientists warn drug-resistant 'killer fungus' is spreading worldwide
Scientists have warned the Candida auris is a 'significant medical concern'
Scientists have warned the Candida auris is a 'significant medical concern'